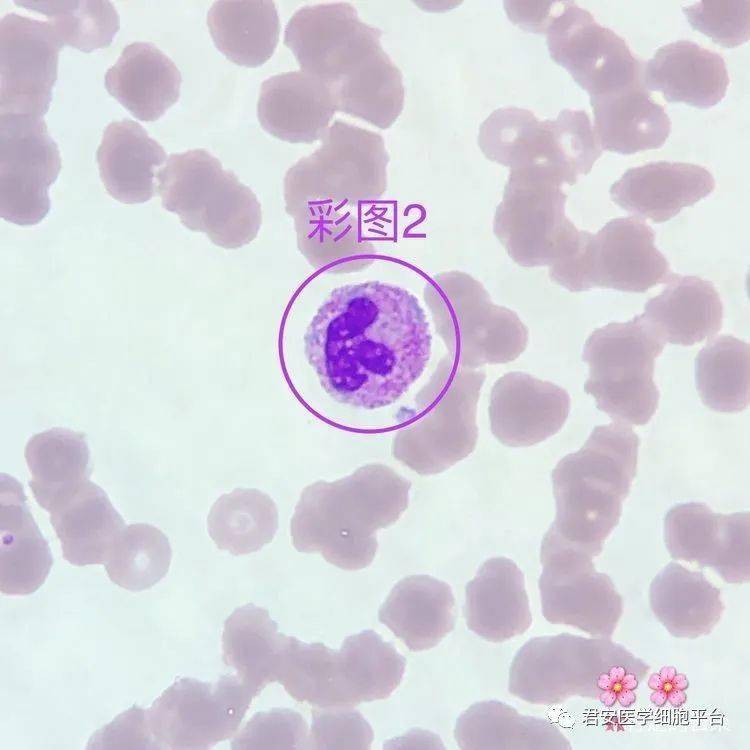
02形态特征:胞体大小均一,呈圆形或类圆形;胞质较少,呈透明的天蓝色

杜勒小体和棒状小体

秀山医学检验质量控制中心第二十六期形态学培训答案解析
图片尺寸1065x1287
▼「auer小体」形态描述:细胞胞质内一根细小的紫红色棒状结构,由胞质
图片尺寸750x563
细胞中的这个小物体连检验科医生都会错过
图片尺寸799x1730
儿童中性粒细胞百分比偏低是什么原因导致的
图片尺寸941x941
杜勒小体 豪焦小体 卡波环 嗜碱性点彩红注意区别#医学检验技术
图片尺寸1080x1439
医生福尔摩斯如何根据检验结果断疾病案
图片尺寸994x994
快速掌握│粒细胞正常与异常形态
图片尺寸441x323
看图识细胞第57期
图片尺寸750x750
罕见的白细胞包涵体,遇见便此生铭记!_腾讯新闻
图片尺寸964x934
2018年细胞形态学培训考试
图片尺寸596x453
胞体较大,细胞直径可达16~25um,核分叶常在5叶,甚至在10叶以上,常见
图片尺寸425x317
接下来又找了几个,有一个粗短的auer小体,直到找到这个柴捆细胞,真的
图片尺寸541x440
白细胞异常散点图背后的真相
图片尺寸456x358
看图识细胞之卫生部2017年第1次血细胞形态学质控
图片尺寸837x654
普通高等教育国家级十一五规划教材 《 组织学与胚胎学 》 理论课件
图片尺寸680x510
杜勒小体
图片尺寸268x179
杜勒小体
图片尺寸478x320
爱爱医资源-哈尔滨医科大学-组织学与胚胎学课件-泌尿系统ppt
图片尺寸1080x810
02形态特征:胞体大小均一,呈圆形或类圆形;胞质较少,呈透明的天蓝色
图片尺寸750x750
第126 期重庆市检验质控中心"金显微镜"形态学培训答
图片尺寸701x470